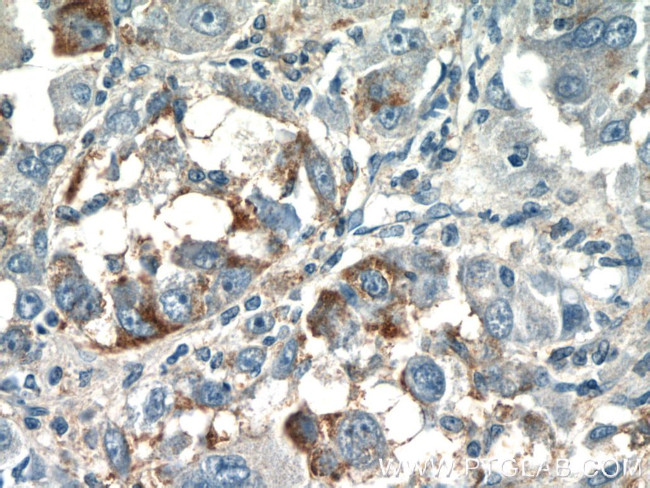
CPPED1 Antibody in Immunohistochemistry (Paraffin) (IHC (P))

Search
Proteintech
CPPED1 Polyclonal Antibody
{{$productOrderCtrl.translations['antibody.pdp.commerceCard.promotion.promotions']}}
{{$productOrderCtrl.translations['antibody.pdp.commerceCard.promotion.viewpromo']}}
{{$productOrderCtrl.translations['antibody.pdp.commerceCard.promotion.promocode']}}: {{promo.promoCode}} {{promo.promoTitle}} {{promo.promoDescription}}. {{$productOrderCtrl.translations['antibody.pdp.commerceCard.promotion.learnmore']}}
产品信息
20628-1-AP
种属反应
宿主/亚型
分类
类型
抗原
偶联物
形式
浓度
规格
纯化类型
保存液
内含物
保存条件
运输条件
产品详细信息
Immunogen sequence: MSAAEAGGV FHRARGRTLD AFPAEKESEW KGPFYFILGA DPQFGLIKAW STGDCDNGGD EWEQEIRLTE QAVQAINKLN PKPKFFVLCG DLIHAMPGKP WRTEQTEDLK RVLRAVDRAI PLVLVSGNHD IGNTPTAETV EEFCRTWGDD YFSFWVGGVL FLVLNSQFYE NPSKCPSLKQ AQDQWLDEQL SIARQRHCQH AIVFQHIPLF LESIDEDDDY YFNLSKSTRK KLADKFIHAG VRVVFSGHYH RNAGGTYQNL DMVVSSAIGC QLGRDPHGLR VVVVTAEKIV HRYYSLDELS EKGIEDDLMD LIKKK (1-314 aa encoded by BC006289)
靶标信息
Protein phosphatase that dephosphorylates AKT family kinase specifically at 'Ser-473', blocking cell cycle progression and promoting cell apoptosis. May play an inhibitory role in glucose uptake by adipocytes.
仅用于科研。不用于诊断过程。未经明确授权不得转售。
篇参考文献 (0)
生物信息学
蛋白别名: Calcineurin-like phosphoesterase domain-containing protein 1; Complete S-transactivated protein 1; Serine/threonine-protein phosphatase CPPED1; unnamed protein product
基因别名: CPPED1; CSTP1
UniProt ID: (Human) Q9BRF8
Entrez Gene ID: (Human) 55313